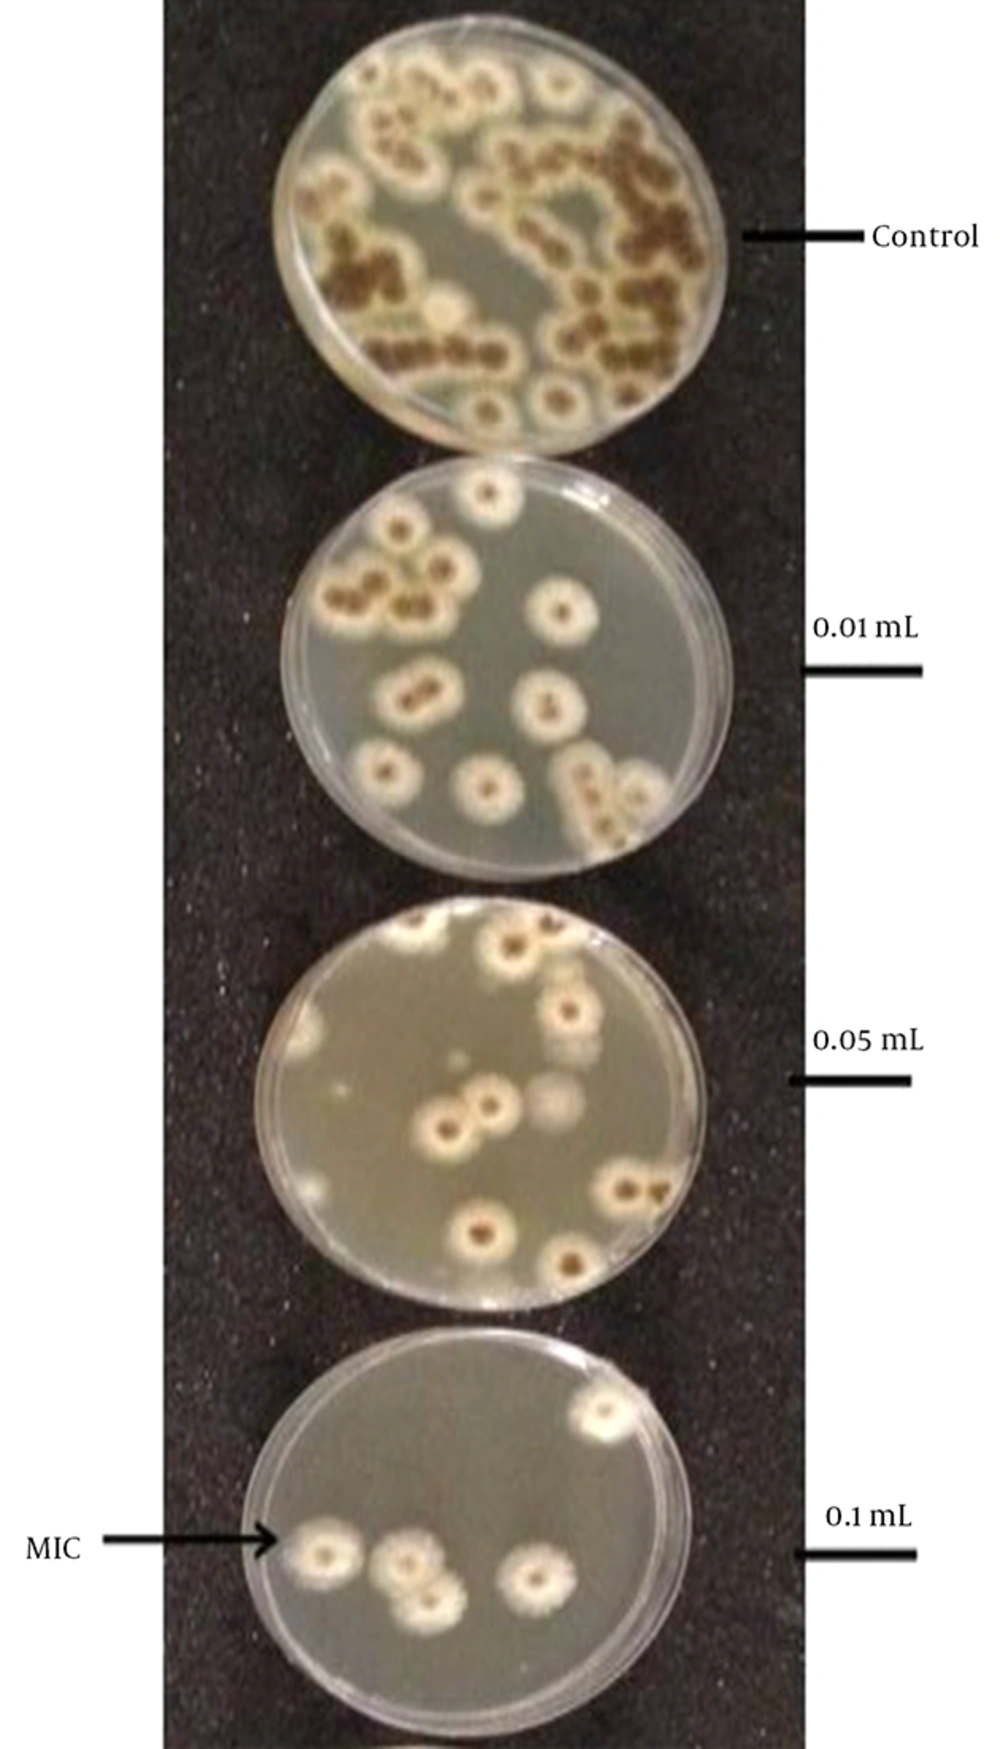

1. Background
Antimicrobials are challenged in fighting infectious diseases due to the developed resistance of microbes (1, 2). One of the proposed solutions to address this issue is to involve nanotechnology through formulating nanoparticles to act as antimicrobials or delivery systems for well-known antibiotics that have some issues in permeating the cell membrane of the microbes. Microemulsions (MEs) are colloidal systems that consist of dispersed nanodroplets produced by mixing oil, water, surfactants, and, most frequently, cosurfactants. The produced MEs can be water-in-oil (w/o) ME, when the oil fraction is larger than the water; oil-in-water (o/w) ME, when the water constituent is greater than that of the oil; or bicontinuous ME, when oil and water fractions are comparable. These systems have been applied extensively in pharmaceuticals, cosmetics, and enhanced oil recovery (3).
To date, research studies on using MEs for antimicrobial purposes are very limited and need further investigation. It was reported that a pharmaceutical ME caused considerable inhibition of the growth of Staphylococcus aureus and Pseudomonas aeruginosa in only 45 seconds (4). Teixeira et al. (5) validated that the o/w ME was active against five bacterial pathogens. Zhang et al. (6) demonstrated the antifungal activity of an ME system that can be used in food technology. Extensive research on soybean oil-based nanoemulsion has shown antibacterial activity against gram-positive bacteria (7). A lipid-based nanoemulsion has shown antibacterial activity against Staphylococcus aureus (8). A recent study implemented by Al-Adham and his collaborators (9) demonstrated the effective antimicrobial activity of a microemulsion consisting of 17.3% Tween 80, 8.5% n-pentanol, 5% isopropyl myristate, and 69.2% sterile distilled water against Candida albicans, Aspergillus niger, Schizosaccharomyces pombe, and Rhodotorula species.
2. Objectives
The aim of this study was to evaluate the antifungal and antiviral activities of three biocompatible ME formulations: o/w MEa with hydrophilic nanodroplet, w/o MEb with hydrophobic nanodroplet, and the bicontinuous MEc.
3. Methods
3.1. Chemicals
Sorbitan monolaurate (Span 20) was purchased from Sigma-Aldrich, USA. Polyoxyethylene sorbitan monooleate (Tween 80) was obtained from El-Nasr pharmaceutical chemical company, Egypt. Sodium pentane sulfonic acid, isopropyl myristate (IPM), and ethanol (99%) were purchased from Jamjoom Pharma, Saudi Arabia. All of the reagents of the viral tissue culture were obtained from King Abdulaziz University hospital, Jeddah, Saudi Arabia.
3.2. Tested Microorganisms
The toxigenic fungi Aspergillus niger (ATCC 1015), Asparagillus flavus (ATCC 204304), Bacillus cereus (ATCC 14579), Candida albicans (ATCC 10231), Candida glabrata (ATCC 200989), the herpes simplex virus type 2 (HSV-2) (strain G; ATCC VR734), and the cell line of the African green monkey kidney (ATTCCCCL 81 (VERO)) were obtained from King Abdulaziz University hospital, Jeddah, Saudi Arabia. All the tested fungi were maintained on slopes of PDA at 4°C. The entire organisms were regenerated every six months.
3.3. Preparation of Microemulsions
Microemulsion formulations MEa, MEb, and MEc were produced, as illustrated in Table 1, by mixing different volume fractions of Tween 80, Span 20, IPM, and water that contained 40% ethanol, as described by Tsai et al. (10).
| Formula | Span 20 | Tween 80 | IPM | Distilled Water (40% Ethanol) | S/O |
|---|---|---|---|---|---|
| MEa | 0.203 | 0.294 | 0.153 | 0.350 | 3.248 |
| MEb | 0.166 | 0.242 | 0.506 | 0.086 | 0.806 |
| MEc | 0.231 | 0.336 | 0.234 | 0.199 | 2.423 |
3.4. Characterization of Microemulsion Droplets Using TEM
The morphologies of the ME droplets were determined using TEM at the faculty of science, King Abdulaziz university. A few drops of the desired ME formula were placed on copper electron microscope grids for 5 minutes. The excess sample was dabbed with filter paper. Then, a 1% droplet of the stain phosphotungstic acid, diluted in distilled water, was added to the grid surface for 30 seconds, after which the excess stain was dabbed with filter paper. Subsequently, the grid was washed with distilled water and the excess water was dabbed. Finally, the sample was observed by TEM. The measurements were performed at 25 ± 0.2°C.
3.5. Antifungal Activity
3.5.1. Solid Medium Diffusion
This test was carried out as described by Perez et al. (11). A volume of 15ml of sterilized PDA medium was poured into each Petri dish (90 mm diameter) and allowed to solidify. All Petri dishes were incubated with freshly prepared inoculums, which were spread over the whole surface of the medium, rotating the dish 60 degrees after each application by using a sterile cotton swab, to ensure the complete spread of the tested fungus on the surface of the plate. One well of 7 mm diameter was bored in the medium of each plate by using a sterile cork-borer. A volume of 100 µL of different MEs (MEa, MEb, and MEc) was placed in each well. Petri dishes were left for 45 minutes at 25°C in order to have an appropriate distribution of the MEs in the PDA medium; they then were incubated for 48 hours at 28°C. The inhibition zones of fungal growth were measured in millimeters. All experiments were performed three times, and the reported data was expressed as: X̅±SD
3.6. Cytotoxicity Test Against Mitochondria Using MTT Assay
The cytotoxic effect of MEb on the fungi mitochondria was determined by measuring the activity of dehydrogenase enzymes using the MTT (3-(4, 5-Dimethylthiazol-2-yl)-2, 5- Diphenyltetrazolium Bromide) assay (12). The A. niger cells were inoculated in Sabouraud medium (50 µL) in a microtiter of 96 wells containing 2 × 105 cells per well and 50 µL of the tested ME formula, previously filtered by bacterial filter (0.45 µm). The microtiter plates were incubated for 24 hours at 37°C and then were centrifuged at 10,000 rpm for 15 minutes in order to collect the precipitated cells while the supernatant was removed. Next, approximately 50 µL of MTT salts was added to each well and incubated for 2 hours at 37°C. The plates were then centrifuged to collect the stained cells and remove the supernatant. A volume of 550 µL of solubilization buffer (27 mL isopropanol, 3 mL triton X100, 2.5 µL HCl, or DMSO) was added to each well of the cells. After strong shaking, the tested fungi were measured at 540 nm using an MCC/340 spectrophotometer.
3.7. Determination of Minimum Inhibitory Concentration
The Minimum inhibitory concentration (MIC) for the prepared MEb was calculated using the broth dilution method described by Zhang et al. (6). Different volume fractions of the tested MEb in potato dextrose broth (PDB) were prepared by adding 0.01, 0.05, and 0.1 mL of MEb into a flask containing 10 mL of PDB and 106 spores of A. niger per mL. The flasks were left in a shaker incubator at 200 revolutions per minute for 30 minutes at 28°C. Next, approximately 0.1 mL of each inoculated flask was spread on PDA Petri dishes which were incubated for 48 hours at 28°C to allow fungi growth. The developed colonies were counted, and mean numbers were calculated. Minimum inhibitory concentration was identified as the least concentration required to inhibit the growth of the fungi in the Petri dish. All experiments were carried out in triplicate.
3.8. Determination of Dry Biomass
The dry biomass was measured as described by Lashari et al. (13). A volume of 500 µL of MEb at the dilution determined as MIC was added to 10ml of each spore suspension containing 106 spores of A. niger per mL. Then, they were placed in an incubator shaker at 200 revolutions per minute at 28°C for 48 hours. The culture broth was filtered, and then the filter paper containing the biomass was washed with distilled water, dried at 105 - 110°C in an oven, and weighed. All experiments were carried out in triplicate.
3.9. Leakage of Potassium
A. niger cells were treated with the tested MEb in nutrient broth media, while the control cells were subjected into Amphotericin B. The cells were collected, washed, and suspended in 10 mL distilled water and left in the shaker for 30 minutes. Next, the cells were removed by centrifugation, and the quantity of potassium in the solution was measured using a flame photometer (Kruss, model FP8800).
3.10. Cellular Respiration
The quantity of oxygen consumed by the living cells in the presence or absence of the tested MEb was determined using an oxygraphe. After 5 minutes of incubation at room temperature, the quantity of oxygen was determined as μL/mg/h of oxygen and compared with the control.
3.11. Characterization of Cell Morphology
The cell morphologies of the tested samples were determined by observing the cells under the light microscope and scanning electron microscope (SEM). The light microscopy images were taken from the samples prepared as illustrated by Sharma and Tribathi (14), while the SEM images of the samples were produced as explained by Zhang et al. (6).
Detection of the antiviral activity of Microemulsions using the cytopathic effect (CPE) assay to evaluate the antiviral activity of MEa, MEb, and MEc against HSV-2, the CPE assay was performed on VERO cells as described by Jadhav et al. (15). Cells were cultured in 96-well microliter plates (2 × 104 cells/100 µL) for 24 hours. The cell control consisted of 200 µL of Dulbecco’s modified eagle medium (DMEM) containing 2% fetal bovine serum albumin and 100 µL of HSV-2 suspension. After one hour incubation of the cell, with 100 µL of various volume fractions of MEb dissolved in DMEM (0.05, 0.01, 5× 10-3, 1 × 10-3, 5 × 10-4, 3.3 × 10-4, 2.5×10-4), the HSV-2 was added to the plates, which were then cultivated for 48 hours in 5% CO2 at 37°C. Next, the plates were washed with saline and stained with crystal violet for 30 minutes at room temperature. Finally, plates were gently washed under running tap water and left overnight for drying and analysis.
3.12. Statistical Analysis
Data was represented as mean ± standard deviation (X̅±SD). Statistical analysis was carried out with one-way analysis of variance (ANOVA), and the measured P value < 0.05 was considered significant.
4. Results
4.1. Characterization of the Microemulsion Formulations Using TEM
Three ME formulations (MEa, MEb, and MEc) were produced by mixing different volume fractions of Span 20, Tween 80, IPM, and water containing 40% ethanol. MEb had the lowest S/O ratio, unlike MEa and MEc, which had similar S/O ratios. As revealed by the transmission electron micrographs in Figure 1, all ME formulations (MEa, MEb, and MEc) had spherical droplets. The measured average diameters (nm) of MEa, MEb, and MEc were 9.4 ± 1.53, 4.7 ± 1.22, and 7.06 ± 1.31, respectively.
4.2. Antifungal Activity
According to the solid medium diffusion, very weak effects of MEa, MEb, and MEc on C. glabrata, Bacillus, and C. albicans were detected. However, MEb was more active against A. niger (Figure 2), as the inhibition zone of MEb was 19.3 ± 2.1 mm. The MIC of MEb that inhibited the germination of A. niger after 30 minutes was 0.1 mL/10 mL of PDB, as revealed by Figure 3. The number of spores of A. niger significantly decreased from 65 to 5 spores when treated with 0.1 mL/10 mL PDB of MEb. Regarding the dry biomass determination, it was found that the percentage decrease in the dry biomass of 0.1 and 0.2 mL of MEb were 22.22 ± 3.35 and 2.78 ± 0.81, respectively. According to the MTT assay, the percentage of cell viability of A. niger subjected to MEb was 45.91 ± 5.06.
The leakage of potassium study found that the potassium flow (×10-7moles of K+/108 CFU/mL) from A. niger subjected to MEb was 0.97 ± 0.01, which was significantly greater than the untreated cells, which had potassium flow of 0.25 ± 0.04. On the other hand, MEb did not affect the respiration of A. niger. In particular, the amounts of oxygen (µL/mg/h) of the cells untreated and treated with MEb were 18.80 ± 0.60 and 18.43 ± 0.50, respectively.
Light microscopy showed that germination of A. niger conidia, incubated in 10 mL of PDB, was inhibited when treated with 0.1 mL of MEb, compared to untreated cells (Figure 4). The surface areas of the treated cells increased, and the conidia enlarged as their volume was enhanced. The morphology of normal and treated A. niger cells incubated in 10 mL of PDB was examined using SEM. As displayed in Figure 5, the morphology of the treated cells changed compared with the untreated cells. The untreated cells contained a huge number of spores with healthy shape and small diameter of the heads of 3.13 ± 0.51 µm. In contrast, the cells treated with 0.1 mL of MEb showed more reduction in the number of spores with abnormal shape, which revealed a significant increase in the diameter of the head of 10.58 ± 0.86 µm and absence of the tail.
4.3. Antiviral Effect of Microemulsions on Enveloped Virus
4.3.1. Cytopathic Effect (CPE) Inhibition Assay
Among the ME formulas, MEb was the only one that affected HSV-2. According to the CPE assay shown in Figure 6, 5 µL/ (1 mL of DMEM) of MEb was sufficient to kill all of the HSV-2 virus. In other words, a 200-fold dilution of MEb was able to destroy the HSV-2 virus.
5. Discussion
In this work, three ME formulations (MEa, MEb, and MEc) were prepared with different S/O ratios as described by Tsai et al., (10) who found that MEb has the smallest droplet size, 122.7 ± 1.8 nm, in agreement with our transmission electron micrographs. In fact, the S/O ratio and the water fraction of the hydrophilic MEa and neutral MEc were higher than the hydrophobic MEb, which is considered water-in-oil ME. Although the ME formulations had different compositions, they had the same spherical shape.
The three ME formulations (MEa, MEb, and MEc) were scanned against four different kinds of fungi, A. niger, A. flavus, Bacillus, C. glabrata, and C. albicans, using solid medium diffusion. Only MEb showed antifungal activity against A. niger, which could be due to the low S/O ratio and small fraction of water present in the formula. A previous study produced ME by mixing the oil, glycerol monolaurate, and the surfactant, tweens (16). It showed that glycerol monolaurate loaded in ME has greater activity than free glycerol monolaurate. In particular, 0.05% of ME was enough to inhibit 78% of A. niger cell growth.
In the current study, the growth of A. niger was entirely suppressed within 30 minutes when the liquid medium containing 106 spores/ml was treated with 0.1 mL of MEb, which was considered the MIC. For further elaboration of the antifungal activity, a light microscope and SEM were utilized. It was noticed that 0.1 mL of MEb enlarged the head of A. niger cells, indicating that the cell membrane of the fungal cells was disrupted and its permeability was enhanced, which resulted in raising the leakage of potassium and the loss of the cellular components that was justified by the reduction in the dry biomass. Our findings are in agreement with Zhang et al. (6), who reported that an oil-in-water ME, consisting of 5% glycerol monolaurate, 15% propionic acid, 21% Tween 80, and 21% sodium benzoate, caused disruption in the cell membrane of A. niger that leads to cell death.
According to the MTT assay and cellular respiration experiment, MEb reduced the A. niger viability without affecting the oxygen consumption. In fact, the MTT assay is based on detecting any structural changes that would occur in succinate dehydrogenase, an enzyme that oxidizes the succinate in the mitochondria of A. niger. MTT assay does not identify any alterations that would occur in other dehydrogenases, such as NADH dehydrogenase, which plays a major role in cellular respiration by oxidizing NADH (12).
The CPE assay was employed to detect the antiviral effect of MEb. It was found that MEb was able to destroy the HSV-2 virus at a 200-fold dilution in DMEM. MEs are involved in formulating many antiviral drugs in order to improve their permeability and efficacy. An ME formula composed of isopropyl myristate, captex 355, labrafac, Tween 20, Span 20, water, and dimethylsulfoxide, was involved in encapsulating an antiviral drug, acyclovir (17). It was found that this formula improved the drug penetration and, hence, its efficiency against HSV-1 infection. Moreover, another ME formula, produced by mixing oleic acid, Cremophor EL, and water, was loaded with penciclovir and improved the drug inhibition of the replication of HSV-1 (18).